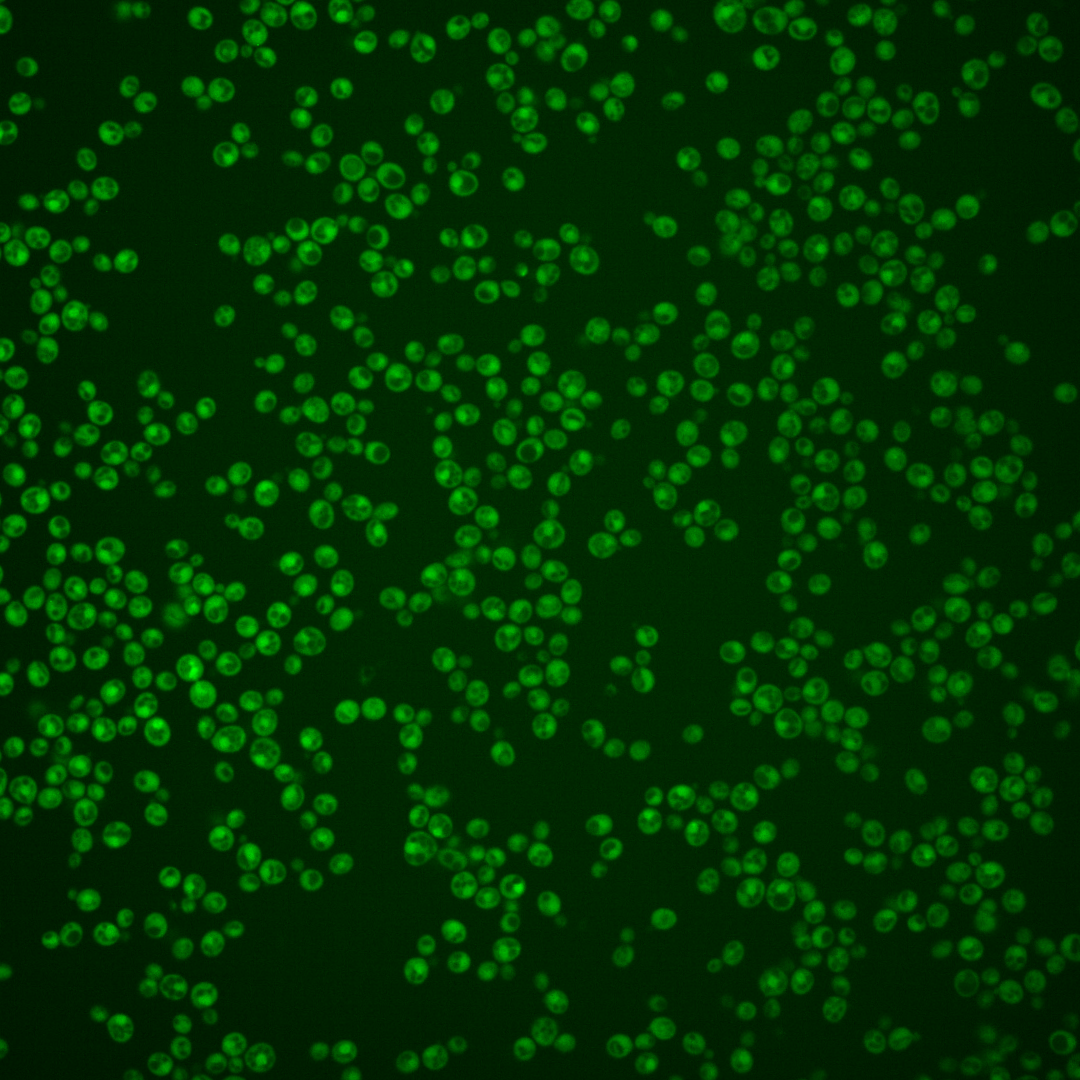
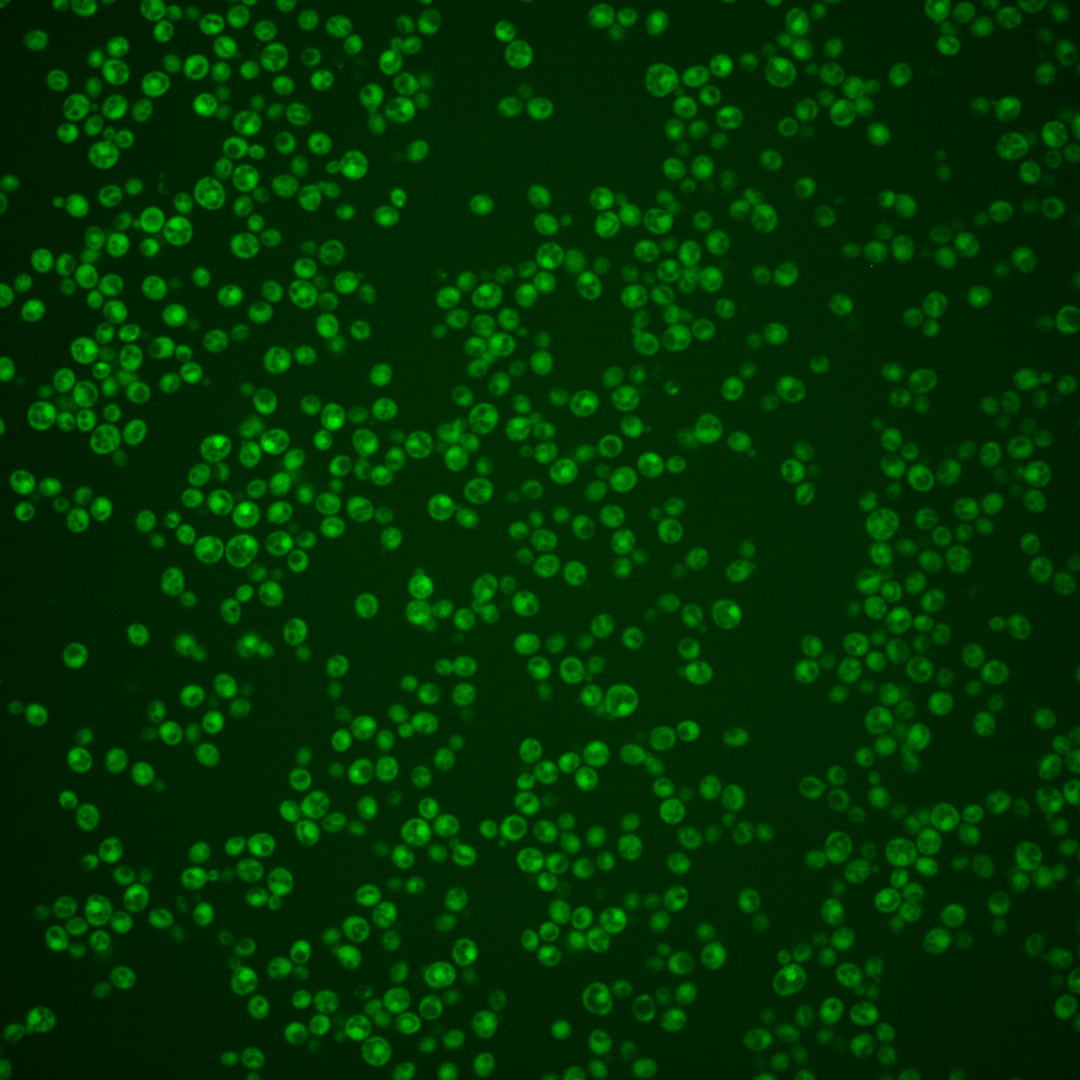
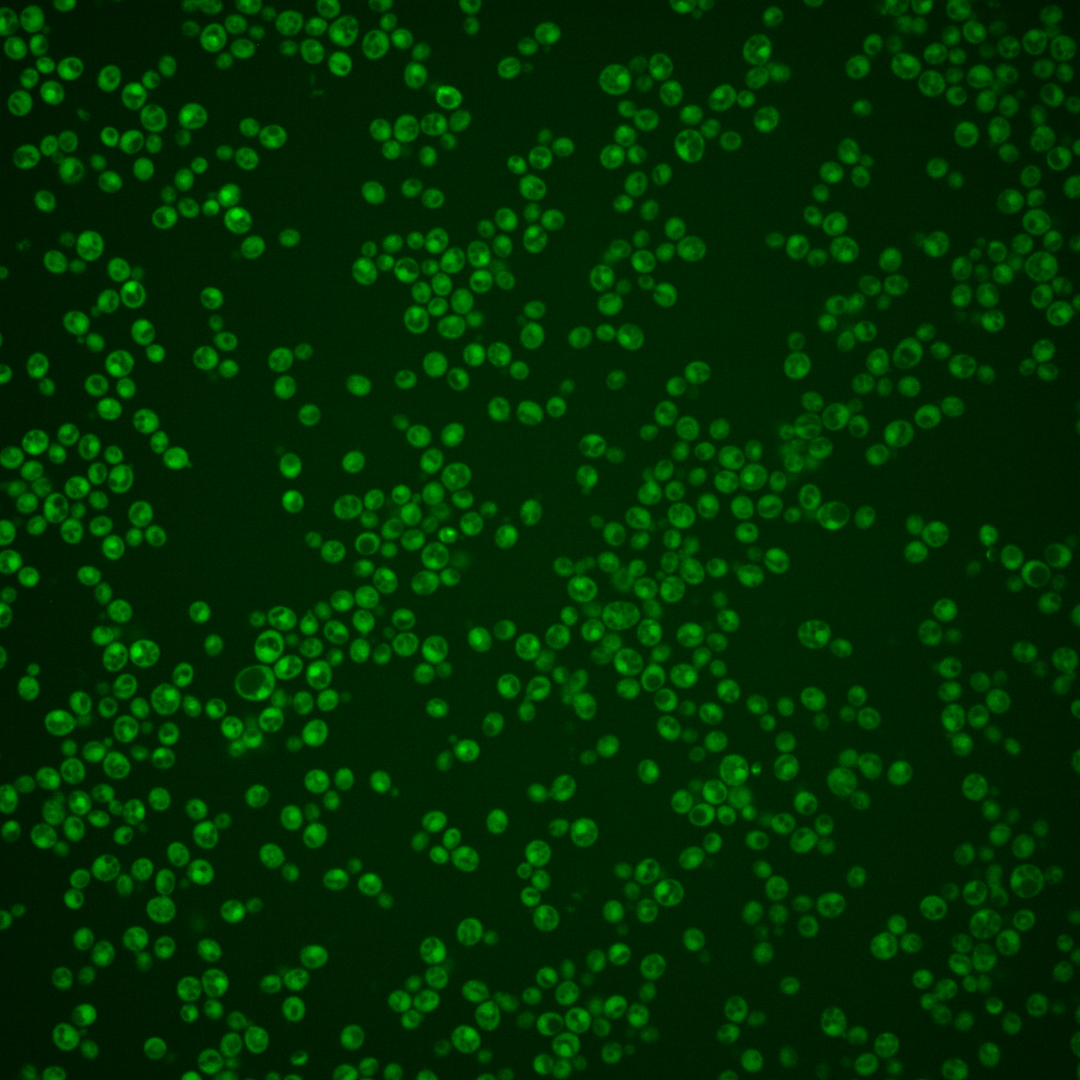

| Standard name | |
|---|---|
| Human Ortholog | |
| Description | Protein that stimulates the ATPase and helicase activities of Prp43p; acts with Prp43p to stimulate 18s rRNA maturation by Nob1p; overexpression antagonizes the suppression of splicing defects by spp382 mutants; component of pre-ribosomal particles; relocalizes from nucleus to nucleolus upon DNA replication stress |
Micrographs




















































































Sub-cellular Localization
Yeast GFP Assignment
Protein Abundance
Localization Change
External localization resources
| ensLOC | DeepLoc | |||||||||||||||||||||||
|---|---|---|---|---|---|---|---|---|---|---|---|---|---|---|---|---|---|---|---|---|---|---|---|---|
| Localization | WT1 | WT2 | WT3 | RAP60 | RAP140 | RAP220 | RAP300 | RAP380 | RAP460 | RAP540 | RAP620 | RAP700 | HU80 | HU120 | HU160 | rpd3Δ_1 | rpd3Δ_2 | rpd3Δ_3 | WT1 | WT2 | WT3 | AF100 | AF140 | AF180 |
| Cortical Patches | 1 | 0 | 0 | 0 | 0 | 3 | 0 | 0 | 0 | 0 | 0 | 0 | 1 | 0 | 0 | 0 | 0 | 0 | 1 | 0 | 0 | 1 | 0 | 2 |
| Bud | 0 | 0 | 1 | 0 | 2 | 10 | 7 | 10 | 10 | 8 | 18 | 11 | 2 | 1 | 1 | 0 | 0 | 0 | 4 | 2 | 2 | 4 | 3 | 8 |
| Bud Neck | 0 | 0 | 0 | 0 | 0 | 1 | 0 | 1 | 0 | 0 | 1 | 0 | 0 | 0 | 0 | 0 | 0 | 0 | 0 | 1 | 1 | 2 | 1 | 3 |
| Bud Site | 0 | 0 | 0 | 0 | 0 | 0 | 3 | 3 | 2 | 1 | 1 | 2 | 0 | 0 | 0 | 0 | 0 | 0 | – | – | – | – | – | – |
| Cell Periphery | 0 | 0 | 0 | 2 | 2 | 2 | 0 | 0 | 3 | 2 | 2 | 4 | 0 | 0 | 1 | 1 | 0 | 0 | 0 | 0 | 0 | 0 | 0 | 0 |
| Cytoplasm | 161 | 42 | 91 | 204 | 408 | 449 | 487 | 473 | 374 | 361 | 394 | 448 | 68 | 219 | 326 | 80 | 107 | 127 | 137 | 34 | 94 | 113 | 162 | 193 |
| Endoplasmic Reticulum | 3 | 0 | 2 | 0 | 1 | 12 | 3 | 0 | 0 | 5 | 0 | 1 | 0 | 11 | 1 | 6 | 7 | 7 | 1 | 0 | 2 | 3 | 3 | 7 |
| Endosome | 8 | 0 | 9 | 13 | 7 | 2 | 1 | 1 | 0 | 2 | 2 | 0 | 5 | 3 | 9 | 19 | 38 | 10 | 15 | 6 | 7 | 1 | 10 | 12 |
| Golgi | 0 | 0 | 0 | 0 | 0 | 0 | 0 | 0 | 0 | 0 | 0 | 0 | 0 | 0 | 0 | 0 | 1 | 1 | 2 | 0 | 0 | 0 | 1 | 4 |
| Mitochondria | 3 | 0 | 28 | 37 | 67 | 176 | 432 | 374 | 300 | 330 | 383 | 374 | 0 | 0 | 0 | 4 | 6 | 1 | 3 | 0 | 4 | 2 | 1 | 7 |
| Nucleus | 25 | 14 | 12 | 1 | 1 | 34 | 25 | 11 | 11 | 9 | 12 | 12 | 15 | 2 | 0 | 18 | 12 | 22 | 80 | 50 | 52 | 10 | 10 | 6 |
| Nuclear Periphery | 0 | 0 | 0 | 0 | 0 | 0 | 5 | 5 | 1 | 3 | 1 | 0 | 0 | 1 | 0 | 0 | 0 | 0 | 2 | 0 | 1 | 0 | 0 | 0 |
| Nucleolus | 0 | 0 | 1 | 2 | 0 | 1 | 1 | 1 | 0 | 0 | 0 | 1 | 0 | 0 | 0 | 1 | 1 | 0 | 5 | 3 | 6 | 0 | 1 | 0 |
| Peroxisomes | 0 | 0 | 0 | 0 | 0 | 0 | 0 | 0 | 0 | 0 | 0 | 0 | 0 | 0 | 0 | 0 | 0 | 0 | 0 | 0 | 0 | 0 | 0 | 0 |
| SpindlePole | 0 | 0 | 0 | 1 | 0 | 2 | 1 | 2 | 0 | 4 | 2 | 5 | 0 | 0 | 1 | 1 | 2 | 0 | 8 | 7 | 19 | 5 | 9 | 7 |
| Vac/Vac Membrane | 129 | 44 | 66 | 16 | 11 | 7 | 32 | 22 | 14 | 18 | 13 | 2 | 58 | 28 | 5 | 94 | 131 | 111 | 29 | 15 | 26 | 30 | 28 | 30 |
| Unique Cell Count | 265 | 86 | 181 | 246 | 459 | 615 | 774 | 743 | 550 | 596 | 634 | 663 | 134 | 252 | 339 | 188 | 239 | 251 | 298 | 124 | 226 | 178 | 241 | 294 |
| Labelled Cell Count | 330 | 100 | 210 | 276 | 499 | 699 | 997 | 903 | 715 | 743 | 829 | 860 | 149 | 265 | 344 | 224 | 305 | 279 | 298 | 124 | 226 | 178 | 241 | 294 |
Yeast GFP Assignment
Protein Abundance
| Screen | WT1 | WT2 | WT3 | RAP60 | RAP140 | RAP220 | RAP300 | RAP380 | RAP460 | RAP540 | RAP620 | RAP700 | HU80 | HU120 | HU160 | rpd3Δ_1 | rpd3Δ_2 | rpd3Δ_3 | AF100 | AF140 | AF180 |
|---|---|---|---|---|---|---|---|---|---|---|---|---|---|---|---|---|---|---|---|---|---|
| Mean Cell GFP Intensity (1e-4) | 6.3 | 6.6 | 4.6 | 4.5 | 4.5 | 3.8 | 3.2 | 3.4 | 3.0 | 3.0 | 2.9 | 3.0 | 6.9 | 6.6 | 6.8 | 7.6 | 7.7 | 7.8 | 7.6 | 7.7 | 8.1 |
| Std Deviation (1e-4) | 0.7 | 0.9 | 0.6 | 1.2 | 1.2 | 0.6 | 0.9 | 1.0 | 0.7 | 0.6 | 0.6 | 0.7 | 1.3 | 1.1 | 1.1 | 1.1 | 1.2 | 1.1 | 2.2 | 2.0 | 2.3 |
| Intensity Change (Log2) | – | – | – | -0.02 | -0.03 | -0.27 | -0.53 | -0.44 | -0.63 | -0.61 | -0.68 | -0.63 | 0.58 | 0.52 | 0.58 | 0.72 | 0.75 | 0.76 | 0.72 | 0.76 | 0.82 |
Localization Change
| Localization | RAP60 | RAP140 | RAP220 | RAP300 | RAP380 | RAP460 | RAP540 | RAP620 | RAP700 | HU80 | HU120 | HU160 | rpd3Δ_1 | rpd3Δ_2 | rpd3Δ_3 |
|---|---|---|---|---|---|---|---|---|---|---|---|---|---|---|---|
| Cortical Patches | 0 | 0 | 0 | 0 | 0 | 0 | 0 | 0 | 0 | 0 | 0 | 0 | 0 | 0 | 0 |
| Bud | 0 | 0 | 0 | 0 | 0 | 0 | 0 | 0 | 0 | 0 | 0 | 0 | 0 | 0 | 0 |
| Bud Neck | 0 | 0 | 0 | 0 | 0 | 0 | 0 | 0 | 0 | 0 | 0 | 0 | 0 | 0 | 0 |
| Bud Site | 0 | 0 | 0 | 0 | 0 | 0 | 0 | 0 | 0 | 0 | 0 | 0 | 0 | 0 | 0 |
| Cell Periphery | 0 | 0 | 0 | 0 | 0 | 0 | 0 | 0 | 0 | 0 | 0 | 0 | 0 | 0 | 0 |
| Cytoplasm | 7.2 | 10.6 | 5.8 | 3.1 | 3.3 | 4.3 | 2.5 | 2.9 | 4.3 | 0.1 | 8.3 | 12.5 | -1.5 | -1.1 | 0.1 |
| Endoplasmic Reticulum | 0 | 0 | 0 | 0 | 0 | 0 | 0 | 0 | 0 | 0 | 2.0 | 0 | 0 | 0 | 0 |
| Endosome | 0 | 0 | 0 | 0 | 0 | 0 | 0 | 0 | 0 | -0.5 | -2.4 | -1.4 | 1.9 | 3.5 | -0.5 |
| Golgi | 0 | 0 | 0 | 0 | 0 | 0 | 0 | 0 | 0 | 0 | 0 | 0 | 0 | 0 | 0 |
| Mitochondria | 0 | 0 | 0 | 0 | 0 | 0 | 0 | 0 | 0 | -4.8 | -6.5 | -7.4 | -4.6 | -4.8 | -6.2 |
| Nucleus | -3.7 | 0 | -0.6 | -2.1 | 0 | -3.1 | 0 | -3.3 | -3.5 | 1.4 | -3.4 | 0 | 1.0 | -0.7 | 0.8 |
| Nuclear Periphery | 0 | 0 | 0 | 0 | 0 | 0 | 0 | 0 | 0 | 0 | 0 | 0 | 0 | 0 | 0 |
| Nucleolus | 0 | 0 | 0 | 0 | 0 | 0 | 0 | 0 | 0 | 0 | 0 | 0 | 0 | 0 | 0 |
| Peroxisomes | 0 | 0 | 0 | 0 | 0 | 0 | 0 | 0 | 0 | 0 | 0 | 0 | 0 | 0 | 0 |
| SpindlePole | 0 | 0 | 0 | 0 | 0 | 0 | 0 | 0 | 0 | 0 | 0 | 0 | 0 | 0 | 0 |
| Vacuole | -7.8 | -11.9 | -14.5 | -12.9 | -13.8 | -12.7 | -12.7 | -13.8 | -15.8 | 1.2 | -6.3 | -11.1 | 2.6 | 3.7 | 1.6 |
External localization resources
Images






























Protein Concentration and Protein Localization Data
| R1 | R2 | R3 | ||||||||||||||||
|---|---|---|---|---|---|---|---|---|---|---|---|---|---|---|---|---|---|---|
| G1 Pre-START | G1 Post-START | S/G2 | Metaphase | Anaphase | Telophase | G1 Pre-START | G1 Post-START | S/G2 | Metaphase | Anaphase | Telophase | G1 Pre-START | G1 Post-START | S/G2 | Metaphase | Anaphase | Telophase | |
| Concentration | – | – | – | – | – | – | – | – | – | – | – | – | – | – | – | – | – | – |
| Actin | 0.0005 | 0.0003 | 0.0007 | 0.0004 | 0.0004 | 0.0004 | 0.0133 | 0.0003 | 0.0003 | 0.0008 | 0.0098 | 0.0044 | – | – | – | – | – | – |
| Bud | 0.0017 | 0.0002 | 0.0021 | 0.0003 | 0.0002 | 0.001 | 0.0005 | 0.0004 | 0.0004 | 0.0045 | 0.0001 | 0.0003 | – | – | – | – | – | – |
| Bud Neck | 0.0009 | 0.0018 | 0.0021 | 0.001 | 0.0014 | 0.004 | 0.0021 | 0.0035 | 0.0025 | 0.0023 | 0.0012 | 0.0052 | – | – | – | – | – | – |
| Bud Periphery | 0.0004 | 0.0001 | 0.0008 | 0.0003 | 0.0001 | 0.0007 | 0.0004 | 0.0002 | 0.0002 | 0.0026 | 0.0001 | 0.0003 | – | – | – | – | – | – |
| Bud Site | 0.0016 | 0.0061 | 0.0035 | 0.001 | 0.0003 | 0.0006 | 0.0022 | 0.0057 | 0.0033 | 0.0018 | 0.0003 | 0.0011 | – | – | – | – | – | – |
| Cell Periphery | 0.0001 | 0.0001 | 0.0001 | 0.0001 | 0 | 0.0001 | 0.0001 | 0.0001 | 0.0001 | 0.0001 | 0 | 0.0001 | – | – | – | – | – | – |
| Cytoplasm | 0.5864 | 0.4987 | 0.5604 | 0.4772 | 0.4339 | 0.569 | 0.5717 | 0.5419 | 0.5648 | 0.4929 | 0.4836 | 0.5312 | – | – | – | – | – | – |
| Cytoplasmic Foci | 0.0301 | 0.0206 | 0.0214 | 0.0112 | 0.0169 | 0.0193 | 0.0291 | 0.0257 | 0.022 | 0.0283 | 0.028 | 0.017 | – | – | – | – | – | – |
| Eisosomes | 0 | 0 | 0.0001 | 0 | 0 | 0 | 0.0002 | 0 | 0 | 0 | 0.0001 | 0.0001 | – | – | – | – | – | – |
| Endoplasmic Reticulum | 0.0113 | 0.0052 | 0.0069 | 0.0038 | 0.0075 | 0.0045 | 0.0122 | 0.0103 | 0.0082 | 0.0089 | 0.0078 | 0.0074 | – | – | – | – | – | – |
| Endosome | 0.0279 | 0.023 | 0.0228 | 0.0119 | 0.0129 | 0.0157 | 0.0351 | 0.0342 | 0.0217 | 0.0201 | 0.0208 | 0.0165 | – | – | – | – | – | – |
| Golgi | 0.0006 | 0.0005 | 0.0005 | 0.0003 | 0.0003 | 0.0003 | 0.0026 | 0.001 | 0.0008 | 0.0005 | 0.0029 | 0.0016 | – | – | – | – | – | – |
| Lipid Particles | 0.0011 | 0.0007 | 0.0009 | 0.0004 | 0.0002 | 0.0003 | 0.0078 | 0.0008 | 0.0012 | 0.0004 | 0.0063 | 0.004 | – | – | – | – | – | – |
| Mitochondria | 0.003 | 0.0006 | 0.0009 | 0.0023 | 0.001 | 0.0008 | 0.0019 | 0.0008 | 0.0006 | 0.0008 | 0.0014 | 0.0024 | – | – | – | – | – | – |
| None | 0.1729 | 0.1982 | 0.2096 | 0.2313 | 0.2052 | 0.1413 | 0.1487 | 0.1285 | 0.1614 | 0.2121 | 0.1724 | 0.123 | – | – | – | – | – | – |
| Nuclear Periphery | 0.0155 | 0.0104 | 0.0118 | 0.0121 | 0.0309 | 0.0099 | 0.0178 | 0.0089 | 0.0104 | 0.0111 | 0.0179 | 0.0105 | – | – | – | – | – | – |
| Nucleolus | 0.0017 | 0.0102 | 0.0024 | 0.0019 | 0.002 | 0.0031 | 0.0023 | 0.0143 | 0.005 | 0.0009 | 0.0009 | 0.0053 | – | – | – | – | – | – |
| Nucleus | 0.1149 | 0.1886 | 0.1339 | 0.2114 | 0.2153 | 0.2005 | 0.1189 | 0.1937 | 0.1685 | 0.1979 | 0.2167 | 0.2429 | – | – | – | – | – | – |
| Peroxisomes | 0.0009 | 0.0003 | 0.0005 | 0.0004 | 0.0004 | 0.0003 | 0.0061 | 0.0004 | 0.0003 | 0.0005 | 0.005 | 0.005 | – | – | – | – | – | – |
| Punctate Nuclear | 0.0177 | 0.0257 | 0.0131 | 0.0273 | 0.0656 | 0.0237 | 0.0163 | 0.0142 | 0.0192 | 0.0084 | 0.0208 | 0.0145 | – | – | – | – | – | – |
| Vacuole | 0.0096 | 0.008 | 0.005 | 0.0043 | 0.0045 | 0.0041 | 0.0095 | 0.0138 | 0.0085 | 0.0045 | 0.0031 | 0.0068 | – | – | – | – | – | – |
| Vacuole Periphery | 0.0012 | 0.0007 | 0.0006 | 0.0009 | 0.0009 | 0.0005 | 0.0011 | 0.0012 | 0.0007 | 0.0007 | 0.0007 | 0.0006 | – | – | – | – | – | – |
Sequencing Data
| R1 | R2 | |||||||||
|---|---|---|---|---|---|---|---|---|---|---|
| G1 Post-START | S/G2 | Metaphase | Anaphase | Telophase | G1 Post-START | S/G2 | Metaphase | Anaphase | Telophase | |
| Gene Expression | 15.5645 | 11.9872 | 13.6602 | 15.145 | 10.2453 | 13.8806 | 15.1503 | 17.3833 | 20.7404 | 18.3066 |
| Translational Efficiency | 1.2887 | 1.1945 | 1.065 | 1.1587 | 1.5796 | 1.5673 | 1.2781 | 0.9348 | 0.9032 | 1.006 |
Hit Data
| Dataset | Hit |
|---|---|
| Protein Concentration | – |
| Protein Localization | ✘ |
| Gene Expression | ✘ |
| Translational Efficiency | ✘ |
Endocytosis
| Temp | Actin Patch (Sac6-tdTomato) | Cortical Patch (Sla1-GFP) | Late Endosome (Snf7-GFP) | Vacuole (Vph1-GFP) |
|---|---|---|---|---|
| 37℃ | ||||
| RT |
Cell Cycle Omics
CYCLoPs (Sqs1-GFP)
| Gene / Allele | Actin Patch (Sac6-tdTomato) | Cortical Patch (Sla1-GFP) | Late Endosome (Snf7-GFP) | Vacuole (Sac6-tdTomato) |
|---|
| Gene | Images |
|---|
| Gene | Images |
|---|
Images are not yet available
Images are not yet available